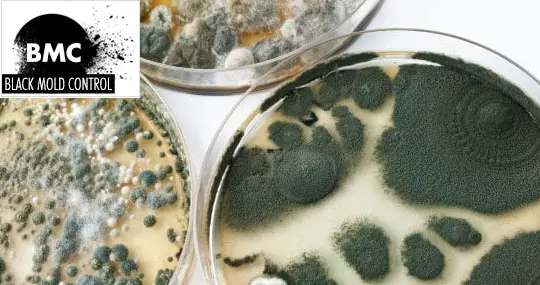

Are you looking for a certified mold inspection company for testing or do you take matter in your own hands with a DIY test kit? Black mold is a serious condition that is becoming all too popular in many homes across the world. It poses many hazards to a person’s overall health when exposure is prolonged.

Table of contents
Why live in a mold infested home?
Of course, people don’t voluntarily live in a home that is infested with black mold but for many, the problem remains undetected until it is too late. Unless mold is visible to the naked eye, many people have no idea that it is in their home. Therefore, it is extremely important to do routine mold testing. A majority of people do this with DIY mold testing kits. However, a more thorough and effective method is to hire a certified professional mold testing and inspection company. Unfortunately, this is also a very expensive option and should be decided carefully.
Do I need a certified inspector?
Not every home needs a certified inspector for testing and inspection and sometimes knowing when to make this decision can be as difficult as finding the mold. Below is a checklist that can be used to determine if this is the right decision.
[su_accordion]
[su_spoiler title=”Are there people in the home that are at a higher risk of being ill?” open=”no” style=”default” icon=”plus” anchor=”” class=””]Infants, the elderly, asthmatics, or people who have comprised immune systems are at the greatest risk. Therefore, if any of these people are living in the house, a certified inspector is a must. [/su_spoiler]
[su_spoiler title=”Are people living in the home sick?” open=”no” style=”default” icon=”plus” anchor=”” class=””]If there are people in the house that are constantly sick and there seems to be no plausible explanation, or if a doctor has suggested that mould exposure might be the culprit, then hiring a professional is a good idea.[/su_spoiler]
[su_spoiler title=”Has there been a situation in which there has been a lot of water damage?” open=”no” style=”default” icon=”plus” anchor=”” class=””]Floods, leaking pipes or roofs, sewer backups, or ventilation problems can all lead to significant water damage. This water damage can result in the growth of mold. If this has happened, it is highly recommended to hire a company and let an inspector do the inspection.[/su_spoiler]
[su_spoiler title=”Do you know you have mold but don’t know the extent?” open=”no” style=”default” icon=”plus” anchor=”” class=””]If there is documented mold growth in the home, there is no way to determine the extent of the problem without hiring a professional. Additionally, this inspector can provide an estimate on the cost of removal and clean-up.[/su_spoiler][/su_accordion]
When to inspect for mold?
Several signs should alert you of the presence of black mold. They include:
Visible spots
If you have black mold in your home, it is easily visible. You will find it cramped in one area of the house. You may notice it spreading or growing in multiple different places in the house.
Musty smell
You may start to notice your home smells of dampness that has a blunt odor. The problem is you won’t know where the musty smell emanates from. It grows in hidden spots making it hard to actually point the finger at the exact place the odor is coming from.
Health complications
These health complications are often associated with the fungi and mostly manifest themselves in symptoms such as coughing, wheezing, asthma attacks, migraines, runny nose, rashes, and headaches. Although these signs aren’t entirely restricted to mold infections if they occur suddenly with no sound explanations you might want to get that inspection.
Recent flooding
If your home has suffered recent water or flood damage, it could have encouraged the growth of black mold.
How to choose a mold inspector?
Once the decision has been made to hire a professional, the next step is to actually hire one. Some tips to keep in mind when choosing a mold inspector are:
- Compare several different companies near your house for price and services.
- Ask friends and family for referrals to inspection companies they have used.
- Ask the company near you for recent referrals. Take the time to call these prior customers to find out how their experience was and if they would use the service again.
- Make sure that a written evaluation is provided that specifically states the areas of the house that were inspected, the cause of the mold, the extent of the growth, how the problem can be fixed, and an approximate cost.
- Make sure that the laboratories that are being used to analyze the mould samples are accredited by either the American Industrial Hygiene Association or by the EPA.
- Check with the Better Business Bureau to learn the status of the company (for example do they use a certified inspector) and to learn if any complaints and/or lawsuits have been filed against them.
As with any service, it is Buyer Beware, but if you do your homework and you know exactly what type of Inspection Company you are contracting with, the process should go smoothly.

What happens during an inspection?
Inspection mainly details the visual inspection of a house. Many people mistake inspection for testing. Here, the inspector only conducts tasks that should reveal the presence of black mold without the use of any special equipment. The professional will use a good flashlight and a blunt tool to help with scrapping off less accessible areas prone to housing fungi. They may also use a moisture meter that aids in determining the wetness of a spot, especially after remediation.
Firstly, the inspector will talk to the property owner about the suspected areas likely to have been infected with the black mold. The owner should also expect to answer if there have been any incidences of water or flood damage in the recent past.
Following permission granted by the owner, the inspector will examine these high prone areas and sometimes even break through walls should he or she suspect hidden grounds. If the black mold presence is apparent, most experts will advise that the owner skip the inspection process and move to the remediation step. Remediation entails on determining the extent of the fungi problem.
Air sampling test
Professional mold testers basically perform two different types of tests: air sampling tests and surface sampling tests. An air sampling consists of taking samples of the air in the home at various times and locations. This type of test will determine if there are mold spores floating around in the home. Traditionally this test is conducted by using a handheld mold sniffer which provides immediate results. Another way to do this test is by sucking air into a cassette that is sealed and sent off to a lab for analysis. Finally, there is the petri dish method, similar to the ones provided in a DIY mold kit.
Surface sampling test
A surface sampling test on the other hand consists of taking samples of the actual fungus. Unfortunately, this test doesn’t provide the exact concentration of spores in the air but it works great to determine the exact type of mold in the house. Surface sampling is done in one of two ways—by using a q-tip like device to swab the mold or by using sticky tape obtain a sample. Either method chosen is then sealed and shipped to a lab for analysis.
Cost of mold inspection
As mentioned above, the cost of hiring a professional mold inspector is not cheap. Depending on the size of the house, the extent of the mould growth, the types of testing done, and the equipment used the price can range from $200 to $900. It is also important to realize that if any additional paperwork needs to be completed, such as to file an insurance claim, it could involve additional costs.
DIY black mold testing
Doctors always say that early detection is the key to effective treatment. This same basic concept should be applied to the issue of black mold. Unfortunately, many people don’t know they have black mold in their homes or if they do notice the signs, they simply clean it up and shrug it off. This can have dire consequences. The recent increase in reported cases of black mold has led to a surge in the testing and inspection business. Luckily for consumers, there are two ways to approach this task. The first is the do-it-yourself method and the second is to hire a professional mold testing company near you. We already mentioned the testing and inspection done by an inspector. Let’s take a closer look at the DIY method.
DIY mold test kits
This is typically the first avenue many people choose because it is much more cost effective than hiring a professional inspection company and the results are given rather quickly–usually within ten to fourteen days. Not to mention they are rather easy to use. All of the kits come equipped with a medium that is located on a stick or in a petri dish. The medium is typically potato dextrose or malt extract that works to promote mold growth.
3 ways to use a mold testing kit
Once the kit is purchased there are three different ways that these DIY mold testing kits can be used. The methods are:
1. Visual Sampling — This is probably the easiest method because all that needs to be done is to take a swab of black mould that is visibly growing.
2. HVAC Air Testing — Another simple method that requires little effort. Simply take a sample from the HVAC system within the home to determine if there is any mold infestation.
3. Settling Plate — This final method is easy yet not as effective. This requires petri dishes to be placed throughout the home in an attempt to capture airborne spores.
Forty eight to seventy two hours after the samples have been collected, if mould is growing then there is an option to send the kit to a lab where the samples will be studied to determine what type of fungi is present and whether or not it is harmful. The one disadvantage to using home kits is that they do not determine how much mould is in the home, only if it is present and whether it is harmful. This can be a serious problem especially in a situation where a person removes visible mold and assumes that the problem is rectified when in reality there is a large amount of toxic black mold hiding in the home.
Are over-the-counter home mold tests reliable?
This question has been a controversy over its accuracy and reliability since most end up being used by “do it yourself” fanatics. If you want to use the testing kit to ascertain the presence of black mold, it may give the results you need despite not being necessary. If there are already apparent signs such as musty smell, recent flood damage, visible black spots and health complications that will ascertain the presence of the fungi. If you are still unsure about it growing in your home, an over the counter testing kit will do the job. If the testing kit confirms with positive results, you may proceed to the next step; remediation.
On the other hand, if you are looking to find out the specific type of black fungi in your house, the test kit may not be your best bet. Specific fungi testing requires samples being sent to the lab for analysis. Only a professional tester can help give the most accurate results.
How to find hidden mold?
One concern many home owners and consumers have is finding hidden mold. Luckily these kits are rather successful at locating hidden mold growth, especially the HVAC air testing and the settling plate methods. If these tests detect mould but it’s not readily visible or if these tests don’t detect it yet there is still a strong suspicion that it is present, it is best to just start doing a visual inspection of the entire house, starting with windowsills, refrigerator seals, around the bathtub, and in the basement. Other areas to look at include behind drywall, wall paper, and in any part of the home that is overly damp and has a consistently high level of humidity.
Top 5 black mold kits
As easy and cost effective as black mold testing kits are, many consumers are overwhelmed by the sheer quantity of kits on the market. Often times a person will become frustrated and decide not to purchase a kit at all or they will end up purchasing the wrong type of kit for what they truly need. Therefore, the top three black mold kits are listed below.
1. DIY mold test kit
Averaging about $50, this kit includes 3 tape lift samples for a surface test. There is also a booklet that is useful for mold inspection in your house. When you have completed your surface test you can sent the samples to a professional lab that processed over 50,000 mold tests.
2. Healthful Home – 5-minute mold test
This black mold home testing kit claims to give results within 5 minutes for Aspergillus/Penicillium and Stachybotrys. With the EPA-recommended dust samples you don’t have to see the mold, so this kit is also useful when you suspect the fungi in your household. You can buy the mold test around $50 and it will include 1 Aspergillus/Penicillium test, 1 rapid test and 1 all-in-one collection swab.
3. Pro-Lab MO109 Household test kit:
This kit includes a single petri dish that can be used to collect samples. It is great for use in bathrooms, bedrooms, living rooms, kitchens, and even the household heating or cooling system. The price is fairly reasonable, ranging from $9 to $15. The only disadvantage to this kit is that it only provides one petri dish so multiple kits would have to be purchased to collect multiple samples and to have the results analyzed by the lab requires an additional $30 fee.
4. EZ-Mold test kit
Averaging about $10, this kit is equipped with a single petri dish and a q-tip for collecting visible black mould samples. Results are usually available 48 to 72 hours after the test is completed and if the fungus is present, they offer the option to send the results to a lab–for a fee of $49.95!
5. First Alert home mold test kit from Wal-Mart
Much more inexpensive than other brands at only $12 for the kit and an additional $12 for the lab to analyze the samples, this kit includes a test strip, baggies to secure the black mold samples, and instructions.